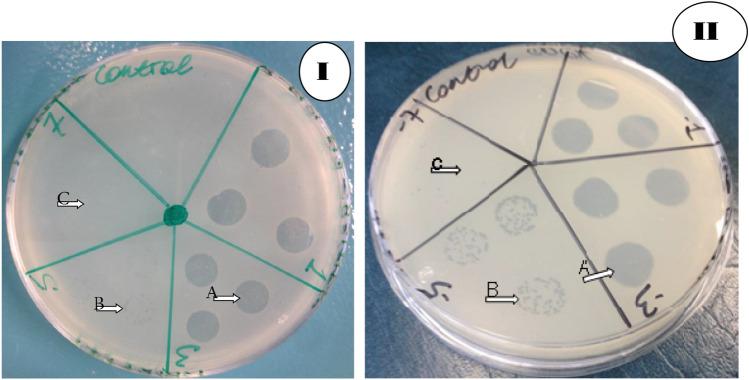
https://cdn.ncbi.nlm.nih.gov/pmc/blobs/e6a7/10861545/2d7603e67f33/41598_2024_53317_Fig1_HTML.jpg

噬菌体对感染糖尿病足溃疡的细菌病原体的裂解活性。
Lytic activity of phages against bacterial pathogens infecting diabetic foot ulcers.
机构信息
College of Science and Engineering, Flinders University, Bedford Park, SA, 5042, Australia.
St Paul's Hospital Millennium Medical College, 1271, Addis Ababa, Ethiopia.
出版信息
Sci Rep. 2024 Feb 12;14(1):3515. doi: 10.1038/s41598-024-53317-4.
Complications of diabetes, such as diabetic foot ulcers (DFUs), are common, multifactorial in origin, and costly to treat. DFUs are the cause of nearly 90% of limb amputations among persons with diabetes. In most chronic infections such as DFU, biofilms are involved. Bacteria in biofilms are 100-1000 times more resistant to antibiotics than their planktonic counterparts. Multidrug-resistant (MDR) Staphylococcus aureus and Pseudomonas aeruginosa infections in DFUs may require alternative therapeutic agents such as bacteriophages ("phages"). This study describes the lytic activity of phage cocktails AB-SA01 (3-phage cocktail) and AB-PA01 (4-phage cocktail), which target S. aureus and P. aeruginosa, respectively. The host range and lytic effect of AB-SA01 and AB-PA01 on a planktonic culture, single-species biofilm, and mixed-species biofilm were evaluated. In vitro testing showed that 88.7% of S. aureus and 92.7% of P. aeruginosa isolates were susceptible to AB-SA01 and AB-PA01, respectively, in the planktonic state. The component phages of AB-SA01 and AB-PA01 infected 66% to 94.3% of the bacterial isolates tested. Furthermore, AB-SA01 and AB-PA01 treatment significantly (p < 0.05) reduced the biofilm biomass of their hosts, regardless of the antibiotic-resistant characteristics of the isolates and the presence of a non-susceptible host. In conclusion, the strong lytic activity, broad host range, and significant biofilm biomass reduction of AB-SA01 and AB-PA01 suggest the considerable potential of phages in treating antibiotic-resistant S. aureus and P. aeruginosa infections alone or as coinfections in DFUs.
糖尿病并发症,如糖尿病足溃疡(DFU),较为常见,其发病机制复杂,且治疗费用高昂。DFU 是导致糖尿病患者近 90%的肢体截肢的原因。在大多数慢性感染(如 DFU)中,生物膜都存在。生物膜中的细菌对抗生素的耐药性比浮游生物中的细菌高 100-1000 倍。DFU 中耐多药(MDR)金黄色葡萄球菌和铜绿假单胞菌感染可能需要替代治疗药物,如噬菌体(“噬菌体”)。本研究描述了针对金黄色葡萄球菌和铜绿假单胞菌的噬菌体鸡尾酒 AB-SA01(3-噬菌体鸡尾酒)和 AB-PA01(4-噬菌体鸡尾酒)的裂解活性。评估了 AB-SA01 和 AB-PA01 对浮游培养物、单种生物膜和混合生物膜的宿主范围和裂解效果。体外试验表明,在浮游状态下,AB-SA01 和 AB-PA01 分别对 88.7%的金黄色葡萄球菌和 92.7%的铜绿假单胞菌分离株敏感。AB-SA01 和 AB-PA01 的组成噬菌体感染了 66%至 94.3%的测试细菌分离株。此外,AB-SA01 和 AB-PA01 处理显著(p<0.05)降低了其宿主生物膜的生物量,无论分离株的抗生素耐药特性和非敏感宿主的存在如何。总之,AB-SA01 和 AB-PA01 的强裂解活性、广泛的宿主范围和显著的生物膜生物量减少表明噬菌体在单独治疗或作为 DFU 中的合并感染治疗耐抗生素的金黄色葡萄球菌和铜绿假单胞菌感染方面具有巨大潜力。